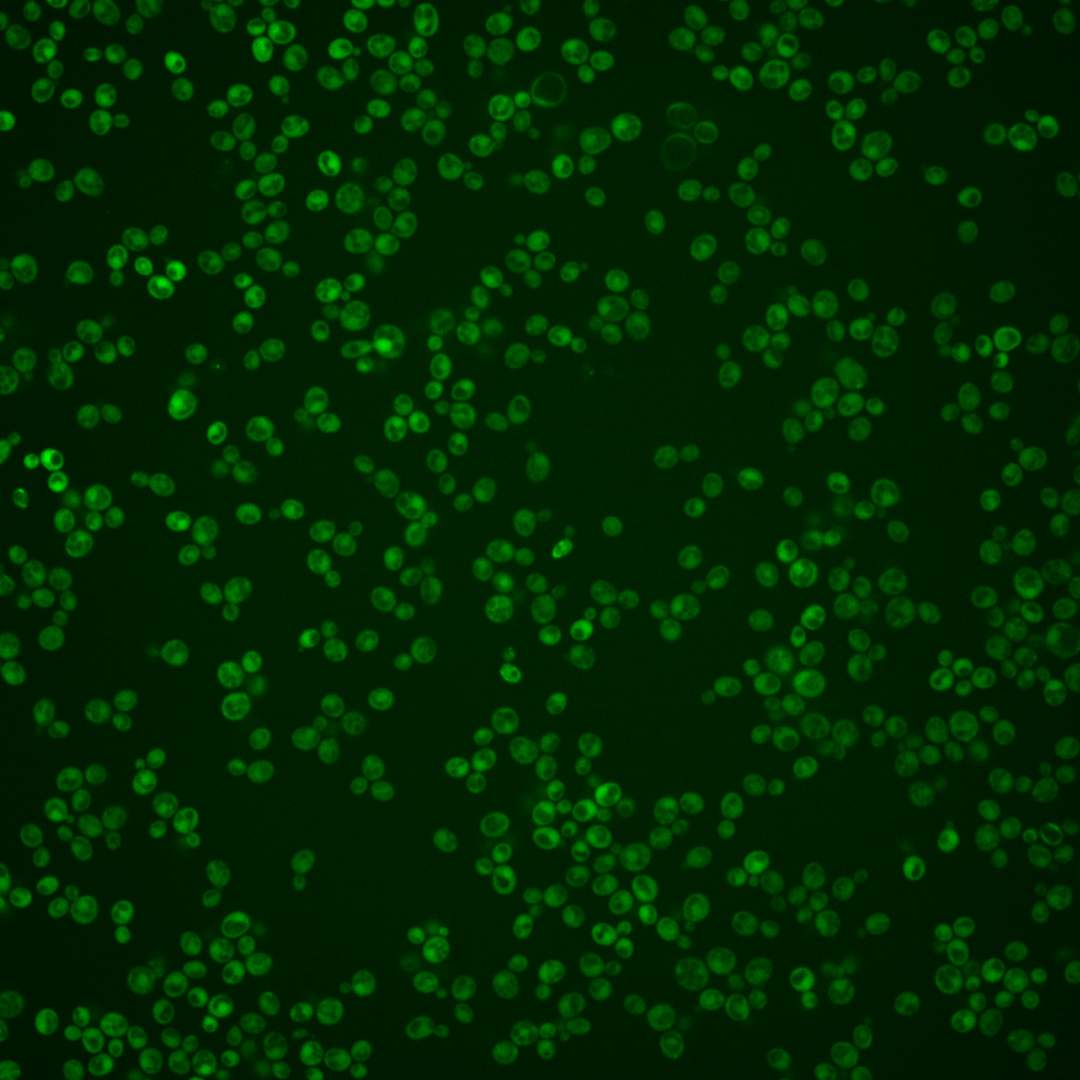
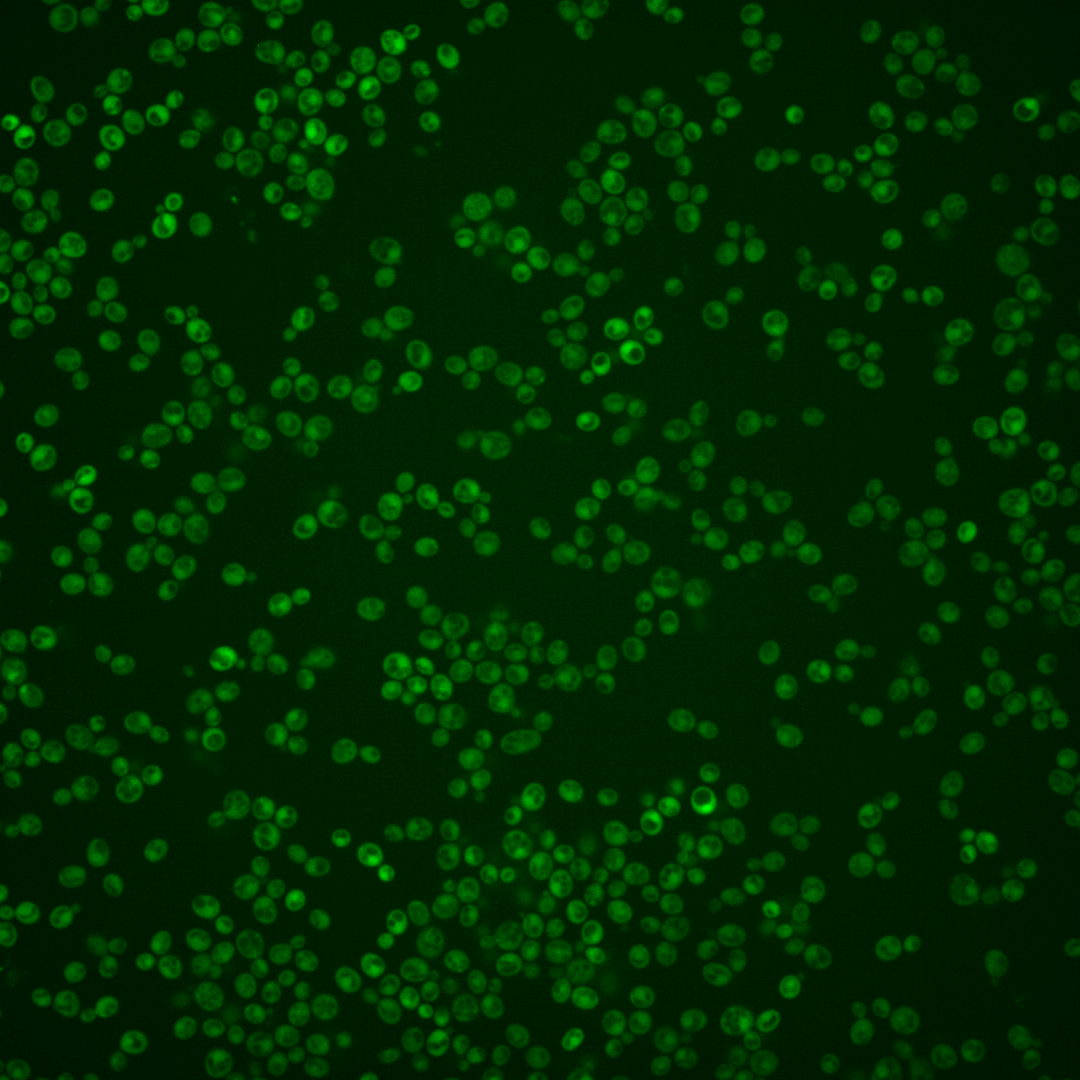
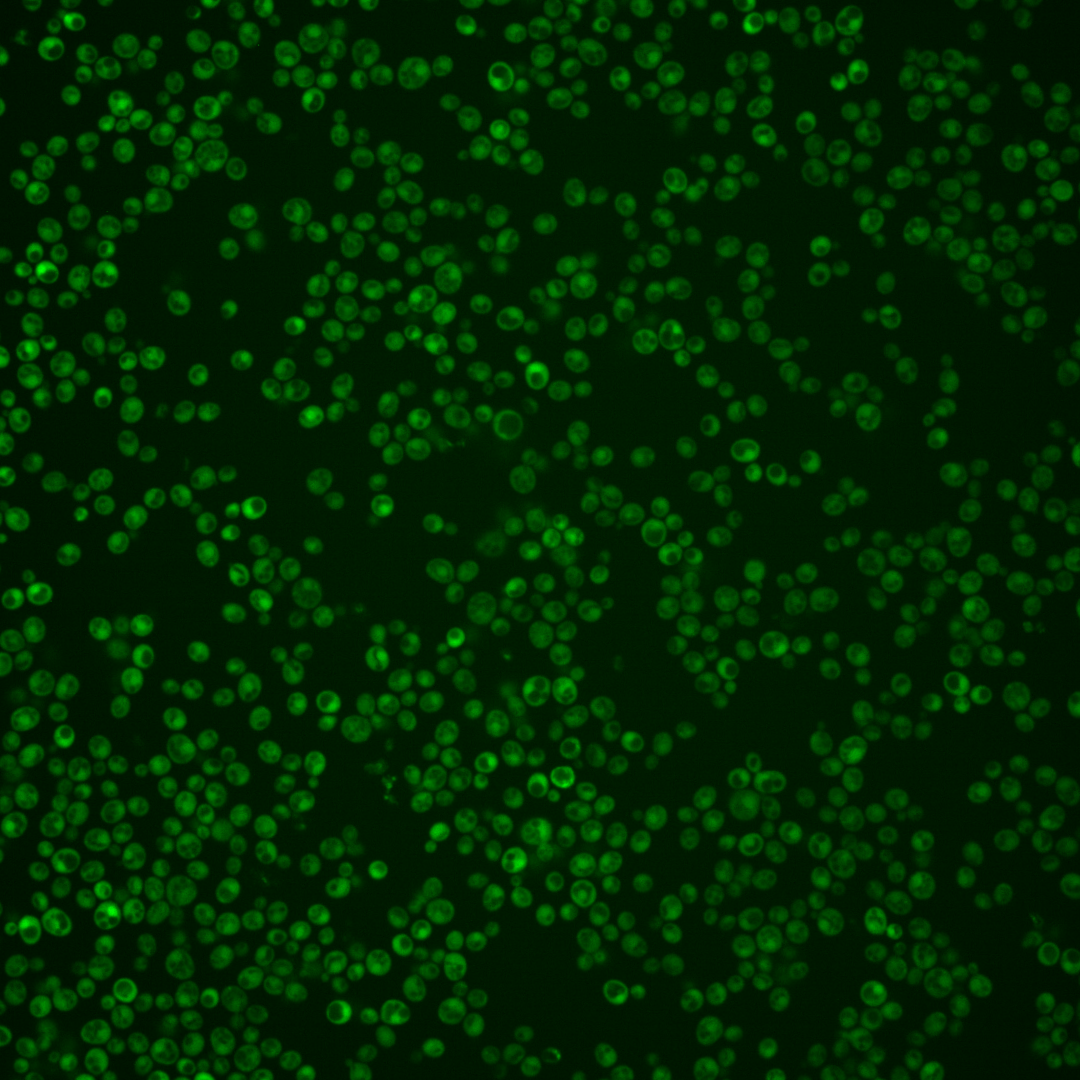
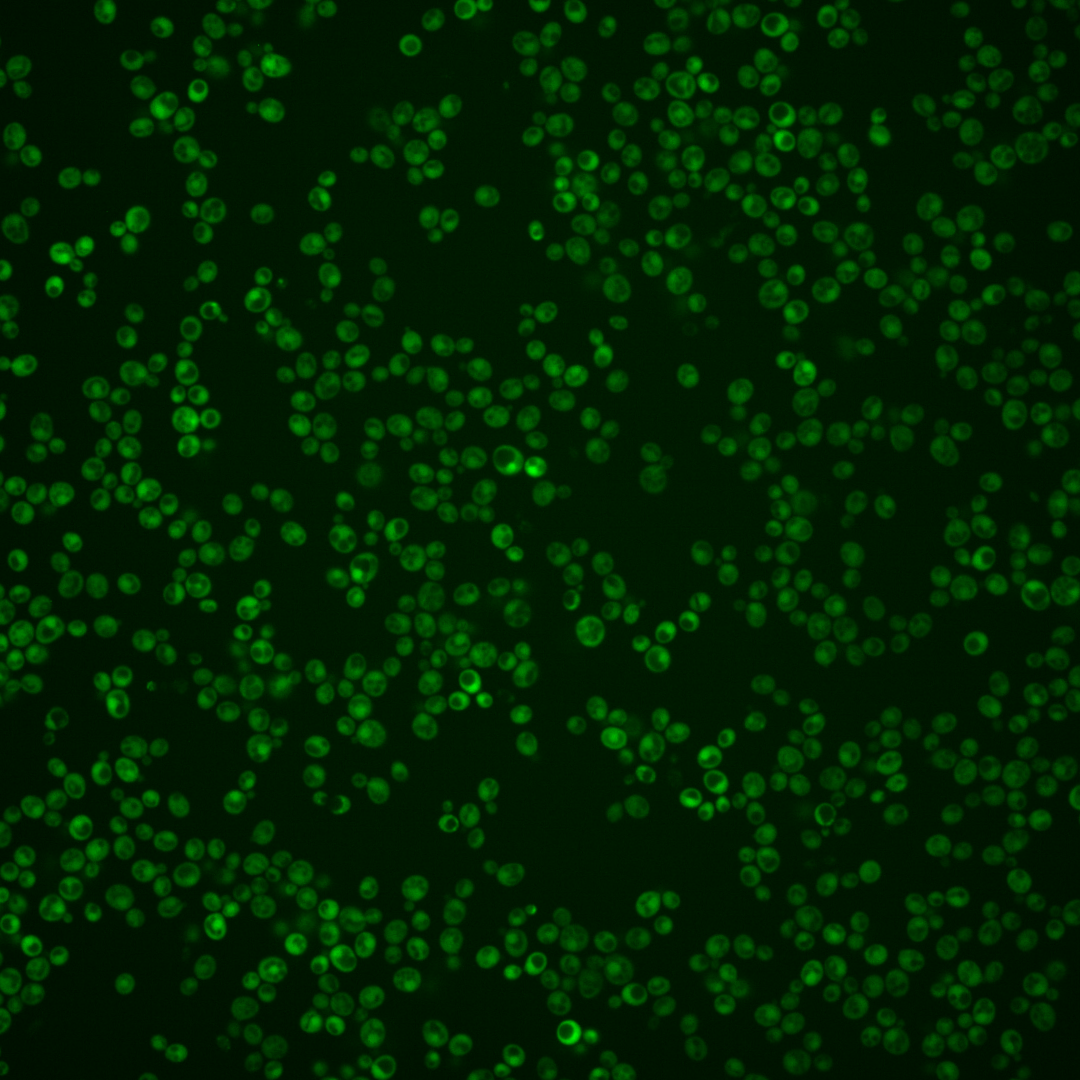
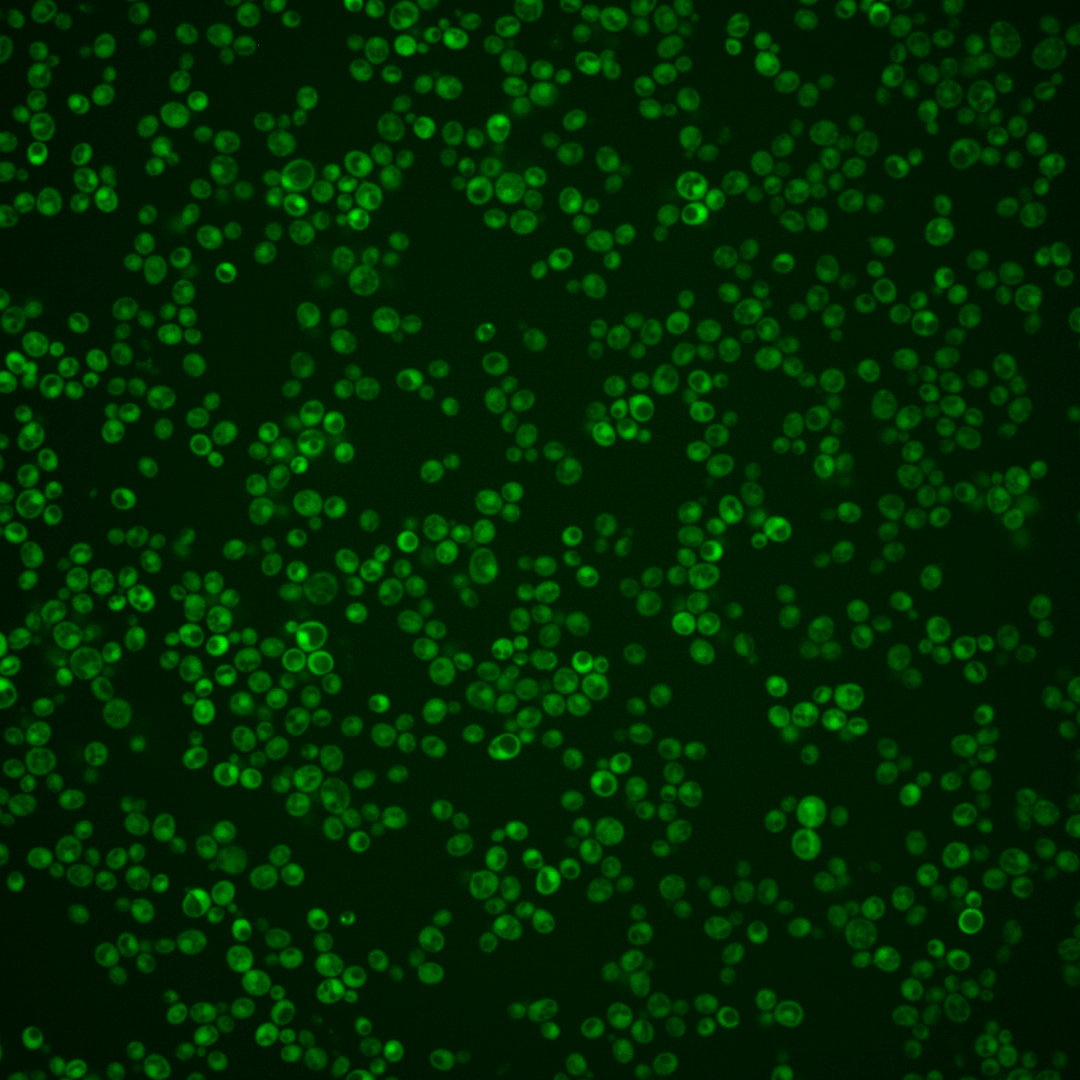
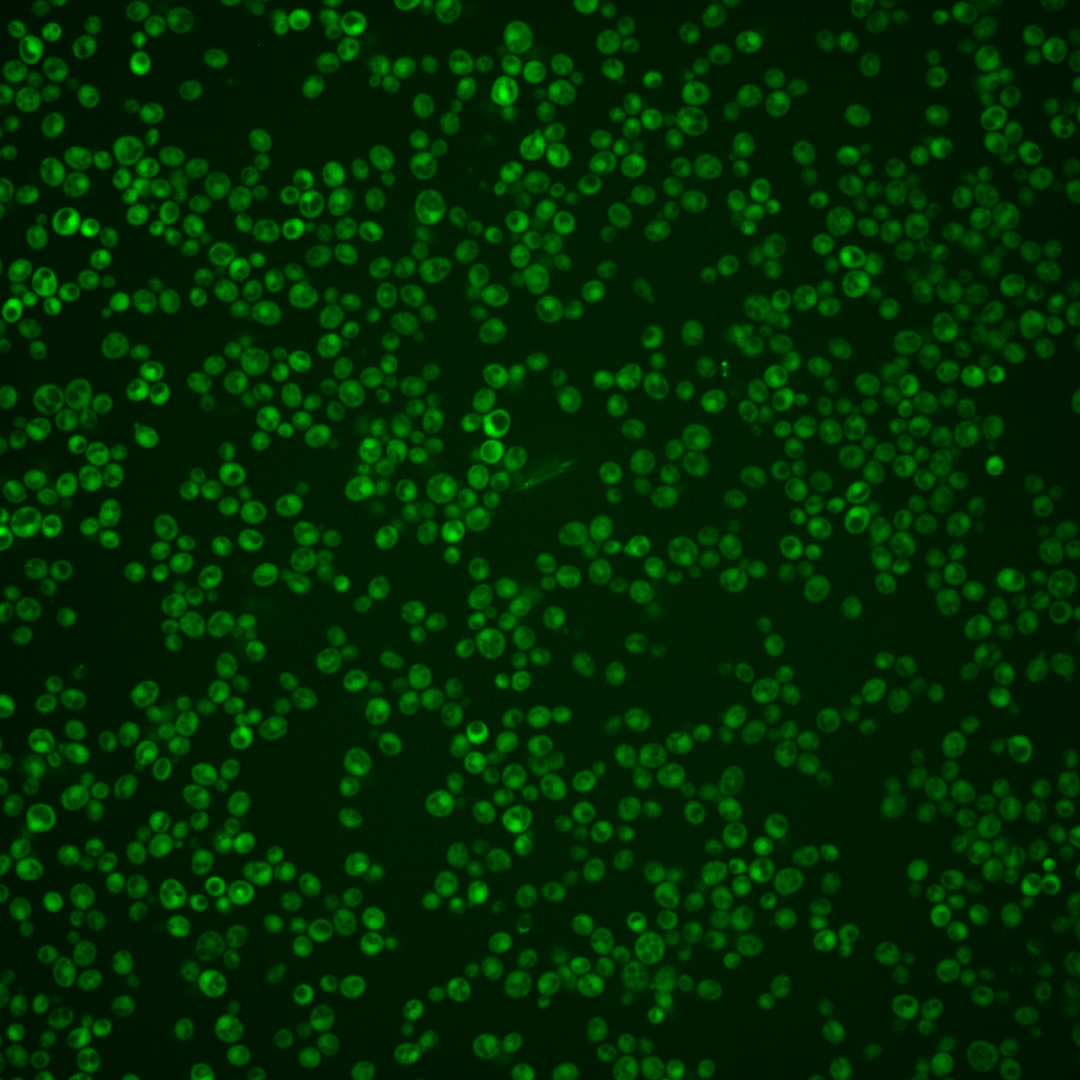

| Standard name | |
|---|---|
| Human Ortholog | |
| Description | mRNA-binding protein expressed during iron starvation; binds to a sequence element in the 3'-untranslated regions of specific mRNAs to mediate their degradation; involved in iron homeostasis; protein increases in abundance and relative distribution to the nucleus increases upon DNA replication stress; TIS11 has a paralog, CTH1, that arose from the whole genome duplication |
Micrographs




















































































Sub-cellular Localization
Yeast GFP Assignment
Protein Abundance
Localization Change
External localization resources
| ensLOC | DeepLoc | |||||||||||||||||||||||
|---|---|---|---|---|---|---|---|---|---|---|---|---|---|---|---|---|---|---|---|---|---|---|---|---|
| Localization | WT1 | WT2 | WT3 | RAP60 | RAP140 | RAP220 | RAP300 | RAP380 | RAP460 | RAP540 | RAP620 | RAP700 | HU80 | HU120 | HU160 | rpd3Δ_1 | rpd3Δ_2 | rpd3Δ_3 | WT1 | WT2 | WT3 | AF100 | AF140 | AF180 |
| Cortical Patches | 0 | 0 | 0 | 0 | 1 | 0 | 0 | 2 | 1 | 0 | 0 | 0 | 0 | 1 | 0 | – | 0 | 0 | 1 | 1 | 5 | 1 | 3 | 3 |
| Bud | 0 | 1 | 0 | 1 | 0 | 1 | 6 | 3 | 8 | 2 | 7 | 6 | 0 | 1 | 0 | – | 0 | 0 | 0 | 0 | 11 | 3 | 4 | 9 |
| Bud Neck | 0 | 1 | 13 | 4 | 7 | 2 | 9 | 16 | 2 | 5 | 6 | 8 | 0 | 0 | 0 | – | 0 | 0 | 0 | 1 | 2 | 0 | 0 | 2 |
| Bud Site | 0 | 0 | 0 | 0 | 0 | 0 | 0 | 0 | 1 | 3 | 0 | 4 | 0 | 0 | 0 | – | 0 | 0 | – | – | – | – | – | – |
| Cell Periphery | 2 | 0 | 4 | 2 | 2 | 1 | 2 | 1 | 2 | 1 | 3 | 1 | 0 | 0 | 0 | – | 1 | 0 | 0 | 0 | 2 | 0 | 1 | 1 |
| Cytoplasm | 146 | 198 | 484 | 365 | 352 | 464 | 446 | 642 | 405 | 427 | 436 | 474 | 131 | 207 | 227 | – | 95 | 117 | 138 | 180 | 387 | 136 | 131 | 144 |
| Endoplasmic Reticulum | 5 | 4 | 0 | 0 | 0 | 0 | 1 | 0 | 1 | 0 | 0 | 0 | 0 | 2 | 0 | – | 9 | 12 | 0 | 0 | 2 | 3 | 3 | 1 |
| Endosome | 1 | 0 | 0 | 0 | 1 | 2 | 0 | 2 | 2 | 0 | 3 | 2 | 0 | 0 | 0 | – | 1 | 5 | 3 | 5 | 5 | 5 | 5 | 7 |
| Golgi | 0 | 0 | 1 | 0 | 0 | 0 | 0 | 0 | 0 | 0 | 0 | 0 | 0 | 0 | 0 | – | 1 | 0 | 2 | 1 | 2 | 4 | 7 | 6 |
| Mitochondria | 7 | 13 | 0 | 10 | 22 | 48 | 75 | 49 | 201 | 122 | 170 | 181 | 0 | 0 | 0 | – | 7 | 4 | 14 | 10 | 28 | 40 | 55 | 39 |
| Nucleus | 0 | 0 | 2 | 1 | 3 | 1 | 8 | 7 | 6 | 4 | 3 | 2 | 2 | 0 | 1 | – | 2 | 0 | 0 | 0 | 1 | 1 | 1 | 0 |
| Nuclear Periphery | 0 | 2 | 0 | 0 | 0 | 0 | 1 | 0 | 1 | 2 | 0 | 2 | 0 | 0 | 0 | – | 0 | 0 | 0 | 0 | 0 | 0 | 1 | 1 |
| Nucleolus | 0 | 0 | 0 | 1 | 0 | 0 | 1 | 2 | 0 | 1 | 0 | 0 | 0 | 0 | 0 | – | 1 | 0 | 0 | 0 | 0 | 0 | 1 | 0 |
| Peroxisomes | 0 | 0 | 0 | 0 | 0 | 2 | 0 | 0 | 0 | 1 | 1 | 0 | 0 | 0 | 0 | – | 0 | 0 | 0 | 1 | 0 | 3 | 3 | 7 |
| SpindlePole | 0 | 0 | 2 | 1 | 1 | 3 | 1 | 11 | 5 | 6 | 6 | 13 | 0 | 1 | 0 | – | 0 | 0 | 1 | 2 | 10 | 6 | 5 | 4 |
| Vac/Vac Membrane | 2 | 3 | 3 | 6 | 1 | 6 | 0 | 6 | 5 | 6 | 7 | 6 | 9 | 18 | 19 | – | 0 | 11 | 3 | 2 | 5 | 2 | 4 | 2 |
| Unique Cell Count | 159 | 212 | 492 | 372 | 362 | 490 | 497 | 703 | 517 | 509 | 549 | 596 | 137 | 220 | 237 | 100 | 132 | 171 | 219 | 482 | 221 | 236 | 237 | |
| Labelled Cell Count | 163 | 222 | 509 | 391 | 390 | 530 | 550 | 741 | 640 | 580 | 642 | 699 | 142 | 230 | 247 | 117 | 149 | 171 | 219 | 482 | 221 | 236 | 237 | |
Yeast GFP Assignment
Protein Abundance
| Screen | WT1 | WT2 | WT3 | RAP60 | RAP140 | RAP220 | RAP300 | RAP380 | RAP460 | RAP540 | RAP620 | RAP700 | HU80 | HU120 | HU160 | rpd3Δ_1 | rpd3Δ_2 | rpd3Δ_3 | AF100 | AF140 | AF180 |
|---|---|---|---|---|---|---|---|---|---|---|---|---|---|---|---|---|---|---|---|---|---|
| Mean Cell GFP Intensity (1e-4) | 3.8 | 3.2 | 5.3 | 5.0 | 4.2 | 3.9 | 3.2 | 4.4 | 3.2 | 3.7 | 3.6 | 3.8 | 16.5 | 14.5 | 13.4 | 4.5 | 5.9 | 6.0 | 6.0 | 6.2 | 6.4 |
| Std Deviation (1e-4) | 0.6 | 1.4 | 1.9 | 2.1 | 1.4 | 1.1 | 1.2 | 1.6 | 1.0 | 1.1 | 1.0 | 1.0 | 4.5 | 3.8 | 3.1 | 2.3 | 2.6 | 2.5 | 2.4 | 1.9 | 2.2 |
| Intensity Change (Log2) | – | – | – | -0.07 | -0.32 | -0.43 | -0.73 | -0.26 | -0.72 | -0.5 | -0.53 | -0.48 | 1.65 | 1.46 | 1.35 | -0.22 | 0.16 | 0.19 | 0.18 | 0.24 | 0.29 |
Localization Change
| Localization | RAP60 | RAP140 | RAP220 | RAP300 | RAP380 | RAP460 | RAP540 | RAP620 | RAP700 | HU80 | HU120 | HU160 | rpd3Δ_1 | rpd3Δ_2 | rpd3Δ_3 |
|---|---|---|---|---|---|---|---|---|---|---|---|---|---|---|---|
| Actin | – | – | – | – | – | – | – | – | – | – | – | – | – | – | – |
| Bud | – | – | – | – | – | – | – | – | – | – | – | – | – | – | – |
| Bud Neck | – | – | – | – | – | – | – | – | – | – | – | – | – | – | – |
| Bud Site | – | – | – | – | – | – | – | – | – | – | – | – | – | – | – |
| Cell Periphery | – | – | – | – | – | – | – | – | – | – | – | – | – | – | – |
| Cyto | – | – | – | – | – | – | – | – | – | – | – | – | – | – | – |
| Endoplasmic Reticulum | – | – | – | – | – | – | – | – | – | – | – | – | – | – | – |
| Endosome | – | – | – | – | – | – | – | – | – | – | – | – | – | – | – |
| Golgi | – | – | – | – | – | – | – | – | – | – | – | – | – | – | – |
| Mitochondria | – | – | – | – | – | – | – | – | – | – | – | – | – | – | – |
| Nuclear Periphery | – | – | – | – | – | – | – | – | – | – | – | – | – | – | – |
| Nuc | – | – | – | – | – | – | – | – | – | – | – | – | – | – | – |
| Nucleolus | – | – | – | – | – | – | – | – | – | – | – | – | – | – | – |
| Peroxisomes | – | – | – | – | – | – | – | – | – | – | – | – | – | – | – |
| SpindlePole | – | – | – | – | – | – | – | – | – | – | – | – | – | – | – |
| Vac | – | – | – | – | – | – | – | – | – | – | – | – | – | – | – |
| Cortical Patches | – | – | – | – | – | – | – | – | – | – | – | – | – | – | – |
| Cytoplasm | – | – | – | – | – | – | – | – | – | – | – | – | – | – | – |
| Nucleus | – | – | – | – | – | – | – | – | – | – | – | – | – | – | – |
| Vacuole | – | – | – | – | – | – | – | – | – | – | – | – | – | – | – |
External localization resources
Images






























Protein Concentration and Protein Localization Data
| R1 | R2 | R3 | ||||||||||||||||
|---|---|---|---|---|---|---|---|---|---|---|---|---|---|---|---|---|---|---|
| G1 Pre-START | G1 Post-START | S/G2 | Metaphase | Anaphase | Telophase | G1 Pre-START | G1 Post-START | S/G2 | Metaphase | Anaphase | Telophase | G1 Pre-START | G1 Post-START | S/G2 | Metaphase | Anaphase | Telophase | |
| Concentration | 4.5546 | 5.1634 | 5.3958 | 4.3528 | 4.7098 | 5.2445 | 5.4977 | 3.6722 | 4.0177 | 4.8982 | 4.1924 | 4.4022 | 1.4463 | 1.7807 | 1.3562 | 1.5871 | 2.2592 | 1.8476 |
| Actin | 0.0232 | 0.0044 | 0.0232 | 0.0007 | 0.0056 | 0.0077 | 0.2615 | 0.0001 | 0.041 | 0.0052 | 0.0021 | 0.0198 | 0.0366 | 0.0017 | 0.0131 | 0.0129 | 0.045 | 0.0036 |
| Bud | 0.0004 | 0.0026 | 0.0015 | 0.0001 | 0.0003 | 0.0001 | 0.0009 | 0.0006 | 0.0004 | 0.0005 | 0.0001 | 0.0002 | 0.0003 | 0.0101 | 0.0002 | 0.0001 | 0.0006 | 0 |
| Bud Neck | 0.0013 | 0.0002 | 0.0005 | 0.0002 | 0.0005 | 0.001 | 0.0065 | 0.0001 | 0.0008 | 0.0013 | 0.0001 | 0.0005 | 0.0002 | 0.0001 | 0.0002 | 0.0001 | 0.0007 | 0.0002 |
| Bud Periphery | 0.0005 | 0.0012 | 0.0016 | 0.0001 | 0.0002 | 0.0001 | 0.0009 | 0.0008 | 0.0005 | 0.0007 | 0.0002 | 0.0002 | 0.0007 | 0.0014 | 0.0002 | 0.0002 | 0.0008 | 0.0001 |
| Bud Site | 0.002 | 0.0048 | 0.0019 | 0.0001 | 0.0008 | 0.0001 | 0.0131 | 0.0003 | 0.0018 | 0.0012 | 0 | 0.0002 | 0.0007 | 0.003 | 0.0006 | 0.0001 | 0.0029 | 0 |
| Cell Periphery | 0.0003 | 0.0003 | 0.0002 | 0.0001 | 0 | 0 | 0.0004 | 0.0002 | 0.0002 | 0.0002 | 0 | 0 | 0.0002 | 0.0002 | 0.0001 | 0 | 0.0001 | 0 |
| Cytoplasm | 0.538 | 0.7793 | 0.632 | 0.7386 | 0.6532 | 0.7883 | 0.171 | 0.4724 | 0.3333 | 0.2116 | 0.3002 | 0.3769 | 0.1371 | 0.2294 | 0.2274 | 0.1952 | 0.1957 | 0.3491 |
| Cytoplasmic Foci | 0.0271 | 0.0057 | 0.0102 | 0.0114 | 0.0281 | 0.0145 | 0.0506 | 0.0031 | 0.0165 | 0.0151 | 0.0553 | 0.0075 | 0.0185 | 0.0124 | 0.0158 | 0.0107 | 0.067 | 0.0038 |
| Eisosomes | 0.0005 | 0.0001 | 0.0002 | 0 | 0 | 0 | 0.0009 | 0.0001 | 0.0004 | 0.0001 | 0.0001 | 0.0001 | 0.0008 | 0.0001 | 0.0002 | 0.0003 | 0.0002 | 0.0001 |
| Endoplasmic Reticulum | 0.0106 | 0.0035 | 0.0054 | 0.0026 | 0.0025 | 0.0033 | 0.0039 | 0.0021 | 0.0052 | 0.0028 | 0.0009 | 0.0013 | 0.0033 | 0.0023 | 0.0021 | 0.0026 | 0.0012 | 0.0013 |
| Endosome | 0.0208 | 0.0027 | 0.0104 | 0.0428 | 0.0163 | 0.0044 | 0.0393 | 0.0022 | 0.01 | 0.0431 | 0.0031 | 0.0042 | 0.0132 | 0.0042 | 0.0135 | 0.0052 | 0.0397 | 0.0022 |
| Golgi | 0.0134 | 0.001 | 0.0086 | 0.0023 | 0.0363 | 0.0025 | 0.0114 | 0.0001 | 0.0074 | 0.0375 | 0.002 | 0.0059 | 0.0081 | 0.0007 | 0.0079 | 0.0045 | 0.0362 | 0.0007 |
| Lipid Particles | 0.0118 | 0.0003 | 0.0097 | 0.0003 | 0.0077 | 0.0002 | 0.0212 | 0.0001 | 0.014 | 0.0111 | 0.0013 | 0.0003 | 0.0109 | 0.0027 | 0.0085 | 0.0027 | 0.0531 | 0.0009 |
| Mitochondria | 0.0097 | 0.0004 | 0.0109 | 0.0011 | 0.0071 | 0.0009 | 0.0035 | 0.0015 | 0.0023 | 0.0264 | 0.0021 | 0.0021 | 0.0181 | 0.0003 | 0.0053 | 0.0014 | 0.0099 | 0.0007 |
| None | 0.3023 | 0.1819 | 0.2674 | 0.191 | 0.2089 | 0.1496 | 0.2854 | 0.5073 | 0.5377 | 0.5818 | 0.5959 | 0.5784 | 0.7191 | 0.7189 | 0.6807 | 0.7576 | 0.4239 | 0.6323 |
| Nuclear Periphery | 0.0059 | 0.0022 | 0.0022 | 0.0009 | 0.0008 | 0.0042 | 0.0477 | 0.001 | 0.0071 | 0.0026 | 0.0002 | 0.0003 | 0.0079 | 0.0019 | 0.0024 | 0.0008 | 0.0016 | 0.0023 |
| Nucleolus | 0.0005 | 0.0002 | 0.0001 | 0 | 0 | 0.0002 | 0.0111 | 0.0001 | 0.0005 | 0.0005 | 0.0001 | 0 | 0.0002 | 0.0002 | 0.0002 | 0.0001 | 0.0006 | 0.0001 |
| Nucleus | 0.0139 | 0.0061 | 0.005 | 0.0048 | 0.005 | 0.0181 | 0.0279 | 0.0028 | 0.002 | 0.0487 | 0.0006 | 0.0006 | 0.0014 | 0.0027 | 0.0017 | 0.0009 | 0.0006 | 0.0011 |
| Peroxisomes | 0.0107 | 0.0002 | 0.0058 | 0.0005 | 0.0249 | 0.0001 | 0.0221 | 0 | 0.0119 | 0.0033 | 0.0345 | 0.0007 | 0.0127 | 0.0036 | 0.0164 | 0.0033 | 0.0902 | 0.0004 |
| Punctate Nuclear | 0.0052 | 0.0015 | 0.0016 | 0.0005 | 0.0009 | 0.0023 | 0.0125 | 0.0003 | 0.0056 | 0.0025 | 0.0011 | 0.0005 | 0.0086 | 0.0029 | 0.0025 | 0.0006 | 0.0275 | 0.0008 |
| Vacuole | 0.0014 | 0.0016 | 0.0011 | 0.0014 | 0.0005 | 0.0016 | 0.005 | 0.0036 | 0.0008 | 0.0024 | 0.0002 | 0.0003 | 0.0006 | 0.0011 | 0.0007 | 0.0004 | 0.0016 | 0.0002 |
| Vacuole Periphery | 0.0006 | 0.0002 | 0.0004 | 0.0005 | 0.0002 | 0.0007 | 0.0032 | 0.0011 | 0.0007 | 0.0012 | 0.0001 | 0.0001 | 0.001 | 0.0002 | 0.0003 | 0.0002 | 0.0009 | 0.0001 |
Sequencing Data
| R1 | R2 | |||||||||
|---|---|---|---|---|---|---|---|---|---|---|
| G1 Post-START | S/G2 | Metaphase | Anaphase | Telophase | G1 Post-START | S/G2 | Metaphase | Anaphase | Telophase | |
| Gene Expression | 39.2236 | 70.127 | 37.5351 | 39.3983 | 12.5054 | 88.6862 | 110.4263 | 133.37 | 106.8842 | 133.2555 |
| Translational Efficiency | 2.539 | 2.1124 | 2.5427 | 1.8511 | 2.4246 | 2.4925 | 2.3241 | 1.8078 | 2.0304 | 1.8958 |
Hit Data
| Dataset | Hit |
|---|---|
| Protein Concentration | ✘ |
| Protein Localization | ✘ |
| Gene Expression | ✘ |
| Translational Efficiency | ✘ |
Endocytosis
| Temp | Actin Patch (Sac6-tdTomato) | Cortical Patch (Sla1-GFP) | Late Endosome (Snf7-GFP) | Vacuole (Vph1-GFP) |
|---|---|---|---|---|
| 37℃ | ||||
| RT |
Cell Cycle Omics
CYCLoPs (Tis11-GFP)
| Gene / Allele | Actin Patch (Sac6-tdTomato) | Cortical Patch (Sla1-GFP) | Late Endosome (Snf7-GFP) | Vacuole (Sac6-tdTomato) |
|---|
| Gene | Images |
|---|
| Gene | Images |
|---|
Images are not yet available
Images are not yet available